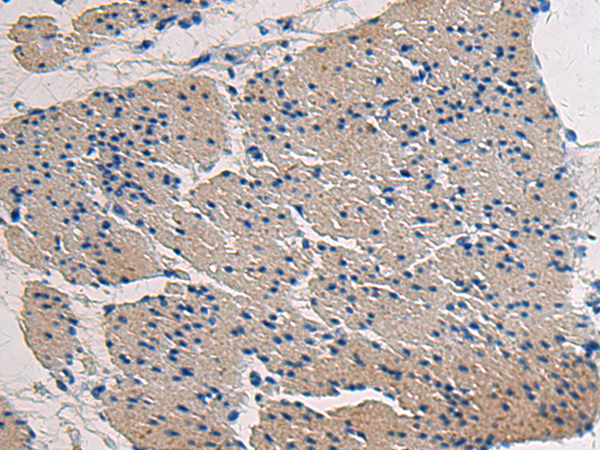

|
Background: |
This gene encodes the alpha chain of type XVII collagen. Unlike most collagens, collagen XVII is a transmembrane protein. Collagen XVII is a structural component of hemidesmosomes, multiprotein complexes at the dermal-epidermal basement membrane zone that mediate adhesion of keratinocytes to the underlying membrane. Mutations in this gene are associated with both generalized atrophic benign and junctional epidermolysis bullosa. Two homotrimeric forms of type XVII collagen exist. The full length form is the transmembrane protein. A soluble form, referred to as either ectodomain or LAD-1, is generated by proteolytic processing of the full length form. |
|
Applications: |
ELISA, IHC |
|
Name of antibody: |
COL17A1 |
|
Immunogen: |
Synthetic peptide of human COL17A1 |
|
Full name: |
collagen type XVII alpha 1 chain |
|
Synonyms: |
ERED; BP180; BPA-2; BPAG2; LAD-1; BA16H23.2 |
|
SwissProt: |
Q9UMD9 |
|
ELISA Recommended dilution: |
5000-10000 |
|
IHC positive control: |
Human gastric cancer and Human breast cancer |
|
IHC Recommend dilution: |
50-200 |

購物車
購物車 幫助
幫助
 021-54845833/15800441009
021-54845833/15800441009
